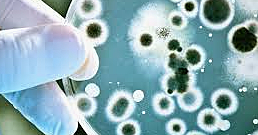
modern medicine

-
The medicine in the middle ages was praying. The doctors diagnosed illness by believing that if your humours were out you would become ill. Doctors would examine the color, smell and taste to find out what was wrong with the patient.
-
Trota Of Salerno was a medial practitioner she promoted cleanness, a balanced diet, exercise, and avoided stress.
-
-
They were treated by local wise woman, the priest, or the barber surgeons who pulled out teeth, set broken bones and preformed other operations. They believed magic and superstitions were the cure at the time. They did have doctors at this time but they only treated the rich. Some had even received medical qualifications from the first medical school in Italy.They had dentists too.
-
-
He was an expert at anatomy. He dissected humans, to study bones, tendons, and muscles. He also studied the human skeletal. He was one of the pioneers in the study of bio-mechanics.
-
Anatomical knowledge was increasing. They were dissecting cadavers. They made a lot of new discoveries of the human body at this time period.
-
At the beginning they still believed magic was the cure to everything. Renaissance meant re-born and roman ideas were being reborn. They were finally able to remove a baby from a women's womb without hurting or killing it. They believed the gods were causing diseases.
-
-
Machines were being invented at this period in time. It advanced the health system. It helped detect diseases and helped cure faster. It helped communication too.
-
The new technology helped resources such as food,clothes,shoes, and jobs. The industrial revolution was all about the machines and new advantages.
-
There wasn't many doctors at this time very little work was made
-
The way people worked in this increased the risk of diseases and other critical conditions. As more people began to travel more diseases were being spread and more contiguous. More and more theories were being told and thought of by scientists.
-
-
In the 19th century the economic growth helped develop and make new scientific discoveries and inventions. It was rapid growth. We were able to identify and cure illnesses more accurately and better.
-
Helped establish the field of pediatric cardiology. She also helped legalize abortion. She became the first female president of American college of cardiology.
-
Way better doctors have been treating serious cases and many cures have been founded. We are still working on curing several stuff. Technology will keep on growing and will be more advanced. Way better stuff is coming
-
We have discovered way new and interesting facts about the human body and new ways to treat the body. New technology has been invented and has the helped the future. New diseases have been discovered and many more will come and impact the community.
-
She is a specialist in diabetes type 1. She is currently in the UK. She helps with the metabolism. She's a famous doctor for this field.
-
Plan projects on a visual timeline
Map milestones, phases, deadlines, and key events in one place so the sequence is easier to see and share. Timetoast is a timeline maker for work, school, research, and stories.